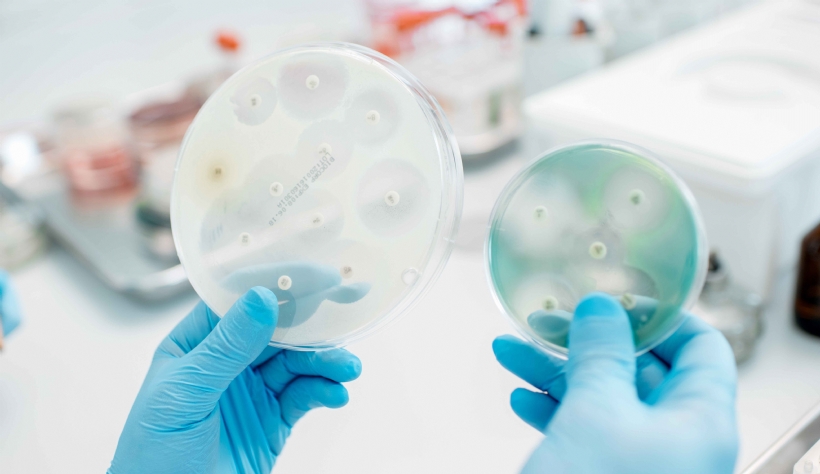

Mieux comprendre les antibiotiques pour mieux les utiliser
Mercredi 11 Juin 2025 Animaux de compagnieL'interprétation des antibiogrammes est un sujet délicat, au coeur de débats entre spécialistes.
© Rh2010 - Adobe
Le Pr Matthias Kohlhauer (pharmacologie clinique, école vétérinaire d'Alfort) est intervenu lors d'une webconférence organisée par le laboratoire Vetoquinol, le 10 avril, animée par notre consoeur Lucile Robin. L'objectif était de faire le point sur la ma...
« Toute reproduction, diffusion, traduction ou exploitation totale ou partielle de nos contenus de quelque nature que ce soit, accessibles gratuitement ou non, sans l’autorisation écrite et préalable de La Dépêche Vétérinaire, est strictement interdite (articles L. 335-2 du Code de la propriété intellectuelle) »